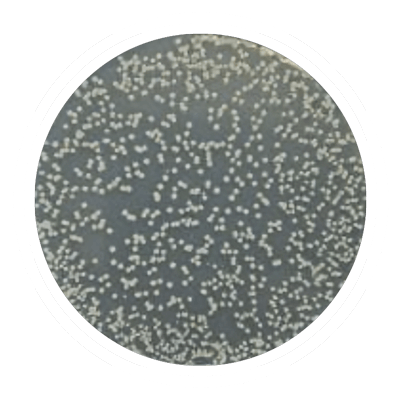

Bring the Heat for recovery that’s fast and complete.

Warm up and get loose with heat
Revolutionary HeatBall™ Technology
Why heat is important?
Massage guns are used to reduce muscle soreness before or after exercise and/or activity. Heat therapy improves circulation and increases blood flow to accelerate muscle recovery. Combining percussive massage and heat therapy will improve your muscle recovery results and experience. Heat, treat, and repeat with HeatBall.

WellBody® delivers 3000 spm and 16 mm of amplitude.
Advanced DeepSpeed™ Percussion
Advanced “DeepSpeed” Percussion - The Holy Grail in massage gun performance is speed at amplitude. Thanks to an all-aluminum powertrain, state-of-the-art design and precision engineering, we provide BOTH high speed AND high amplitude (3,000 spm at 16 mm of amplitude).

ANTI-VIBE BRUSHLESS MOTOR
Virtually, all other massage guns can eventually rattle themselves to death.
Our high-performance, brushless motor is designed to withstand the rigors of daily use and high-speed vibration. We properly secure the motor so it won’t vibrate loose over time, a problem with virtually all other massage guns, which get noisier and can eventually rattle themselves to catastrophic failure.

All-aluminum Powertrain (Plastic-Free)
Aluminum Powertrain resists heat caused by friction to maintain durability.
The drivetrain (motor spindle, arm and shaft connection) is made of premium ADC–12 aluminum. Unlike in many other massage guns, WellBody® has no plastic powertrain parts. This means all parts will withstand the excessive heat caused by friction which effectively reduces the system fatigue that leads to increased noise and premature system failure.

Extra-Long Free-Glide
Aluminum-Bronze Bushing
A superior bushing means greater stability for reduced wear and noise.
WellBody® uses an extra-long, aluminum-bronze bushing (bearing sleeve) which increases overall contact with the reciprocating shaft to provide greater stability and efficiency, which reduces wear and noise.

Composite
Nylon Shell
A shell thats stronger than other massage guns.
The shell on a WellBody® Massage Gun is constructed of an ultra-strong, lightweight, fiberglass-filled composite nylon material that offers exceptional thermal and chemical resistance.

TwistLock
Tip Attachment
Faster, easier and more secure attachment than friction fit used by other massage guns.
HeatBall and other tips are easy to attach and remove. Simply slide the tip into place and give it a quarter turn to lock it into place. This TwistLock system is easier, safer and more secure than the friction fit used by so many other massage guns.
Anti-microbial
Treatment
No other massage gun helps kill bacteria on contact.
The WellBody® shell is impregnated with an antimicrobial treatment that kills bacteria on contact, protecting you and others who may also use the massage gun. This antimicrobial treatment will be effective for the life of the product.

TREATED
UNTREATED